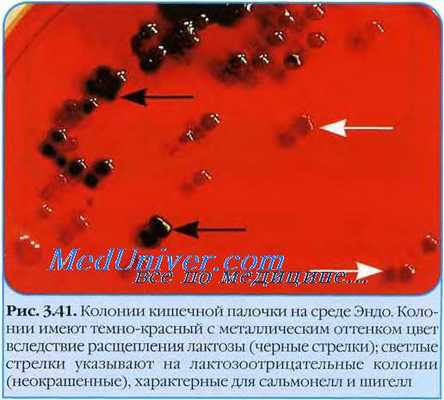
Эшерихии. Эшерихиозы. Свойства эшерихий. Кишечная палочка. Escherichia coli. Морфология кишечной палочки

Микробиологическая диагностика кишечной палочки. Диагностика кишечной палочки. Выявление эшерихий.
Добавил пользователь Alex Обновлено: 03.11.2025
Молекулярно-генетический анализ, который позволяет обнаружить генетический материал возбудителей шигеллеза и эшерихиоза в кале.
Синонимы русские
Шигеллы и энтероизвазивные кишечные палочки (ЭИКП) (эшерихии, колибактерии), возбудители шигеллеза (бактериальной дизентерии) и эшерихиоза.
Синонимы английские
Shigella species and enteroinvasive Esherichia coli (EIEC), DNA, PCR, fecal samples.
Метод исследования
Полимеразная цепная реакция в режиме реального времени.
Какой биоматериал можно использовать для исследования?
Как правильно подготовиться к исследованию?
- Исследование рекомендуется проводить до начала приема антибиотиков и других антибактериальных химиотерапевтических препаратов.
- Исключить прием слабительных препаратов, введение ректальных свечей, масел, ограничить прием медикаментов, влияющих на перистальтику кишечника (белладонна, пилокарпин и др.) и на окраску кала (железо, висмут, сернокислый барий), в течение 72 часов до сбора кала.
Общая информация об исследовании
Shigellaspeciesи Esherichiacoli– грамотрицательные палочковидные микроорганизмы из семейства энтеробактерий. В норме шигеллы и энтероинвазивные кишечные палочки (ЭИКП) отсутствуют в организме. Их выявление указывает на кишечную инфекцию, которая требует лечения пациента и ограничения распространения заболевания.
К роду Shigella относятся патогенные бактерии S. dysenteriae, S. flexneri, S. boydii и S. sonnei, которые являются возбудителями шигеллеза (бактериальной дизентерии).
Бактерии рода E. coli различаются между собой по биохимическим и патогенным свойствам. Не все E. coli, а только некоторые биовары и серотипы колибактерий способны вызывать эшерихиоз. Типичные колибактерии являются представителями нормальной микробиоты кишечника человека, участвуют в процессах пищеварения и относятся к условно-патогенной среде. Кишечные палочки, которые синтезируют и выделяют шигеллоподобный токсин, способствуют развитию эшерихиоза, который протекает по типу инвазивной острой кишечной инфекции (дизентерии). ЭИКП, так же как и шигеллы, могут проникать в клетки слизистой кишечника и разрушать энтероциты, что приводит к образованию язвенных дефектов в слизистой кишечника.
Шигеллы и кишечные палочки распространяются фекально-оральным механизмом передачи, который реализуется пищевым, водным и контактно-бытовым путями.
Инкубационный период составляет от нескольких часов до нескольких дней и зависит от количества бактерий, их патогенных свойств и особенностей защитных механизмов человека. Заболевание может протекать как в легких формах со стертой симптоматикой, так и с развитием тяжелой инфекции. Признаки шигеллеза и энтероинвазивного эшерихиоза схожи: острое начало, резкая боль в животе, многократный стул с примесью слизи и крови, спазм сигмовидной кишки, общая интоксикация.
Около 8 % случаев инвазивного эшерихиоза приводит к гемолитико-уремическому синдрому, который проявляется острой почечной недостаточностью, гемолитической анемией, тромбоцитопенией и пурпурой.
После выздоровления возможно длительное выделение бактерий с калом (характерно для шигеллеза), что способствует распространению инфекции.
Необходимо также учитывать, что существует несколько патологических состояний и кишечных инфекций, которые сопровождаются вышеуказанной симптоматикой, но лечатся по-разному. При обследовании пациента с кровавой диареей необходимо в первую очередь исключить шигеллез, эшерихиоз, амебиаз, отравление химическими веществами, язвенный колит, болезнь Крона, острую кишечную непроходимость и тромбоз сосудов брыжейки.
Для выявления и дифференциальной диагностики кишечных инфекций используются культуральные и молекулярно-генетические методы исследования генетического материала возбудителя в кале и определение концентрации специфических иммуноглобулинов в крови. ПЦР обладает преимуществом перед культуральным методом благодаря быстрому получению результатов и высокой специфичности и чувствительности исследования. Быстрая диагностика острых кишечных инфекций позволяет избежать лишних инвазивных процедур и оперативных вмешательств, своевременно начать лечение и ограничить очаг распространения инфекции.
Микробиологическая диагностика кишечной палочки. Диагностика кишечной палочки. Выявление эшерихий.
Эшерихии. Эшерихиозы. Свойства эшерихий. Кишечная палочка. Escherichia coli. Морфология кишечной палочки. Культуральные свойства кишечной палочки.
Своё название бактерии получили в честь немецкого педиатра Т. Эшериха, впервые выделившего Escherichia coli из содержимого кишечника детей. Род образуют подвижные (перитрихи) прямые палочковидные бактерии размером 1,1-1,5x2,0-6,0 мкм. В мазках они располагаются одиночно или парами. У большинства штаммов существуют капсулы или микрокапсулы.
Температурный оптимум для роста эшерихий 37 °С. Эшерихии ферментируют углеводы с образованием кислоты или кислоты и газа, оксидаза-отрицательны и каталаза-положительны.
Эшерихии входят в состав микрофлоры толстой кишки теплокровных, пресмыкающихся, рыб и насекомых. Эшерихии — основная аэробная микрофлора кишечника, вызывающая, однако, обширную группу заболеваний человека, известных как эшерихиозы.
Эшерихиозы характеризуются не только клиническим полиморфизмом, но и создают особую эпидемиологическую ситуацию. Основное медицинское значение имеет кишечная палочка (Escherichia coli). Кишечные палочки рассматривают как санитарно-показательные микроорганизмы (СПМ) при анализе воды и пищевых продуктов.
Кишечная палочка. Escherichia coli
В настоящее время среди прочих энтеробактерии кишечная палочка — основной возбудитель эшерихиозов у человека.
Морфология кишечной палочки. Культуральные свойства кишечной палочки
Кишечная палочка имеют типичную для энтеробактерий форму и представлены короткими подвижными палочками с закруглёнными концами.
• На плотных средах бактерии образуют плоские выпуклые мутные S-колонии с ровными или слегка волнистыми краями (3-5 мм в диаметре) либо сухие плоские R-колонии с неровными краями.
• В жидких средах растут диффузно, вызывая помутнение среды и образование осадка (реже формируют поверхностную плёнку или пристеночное кольцо).
• На средах Хисса кишечная палочка может образовывать газ. На селективно-дифференциальных средах колонии принимают цвет, соответствующий окраске среды. На агаре Эндо лактоза-положительные эшерихии образуют фукс и ново-красные колонии с металлическим блеском, лактоза-отрицательные — бледно-розовые или бесцветные с тёмным центром. На среде Левина бактерии формируют тёмно-синие колонии с металлическим блеском, а лактоза-отрицательные — бесцветные, на среде Плоскирева — соответственно красные с жёлтым оттенком или бесцветные. На КА могут давать полный гемолиз.
Информация на сайте подлежит консультации лечащим врачом и не заменяет очной консультации с ним.
См. подробнее в пользовательском соглашении.
Посев кала на патогенные эшерихии – лабораторное исследование для диагностики инфекций желудочно-кишечного тракта, вызываемых патогенными штаммами кишечной палочки.
Посев на энтеропатогенную кишечную палочку.
Escherichia coli Detection in Stool Samples, Shiga toxin-producing Escherichia coli.
Кал, ректальный мазок.
- Исследование рекомендуется проводить до начала приема антибиотиков и других антибактериальных химиотерапевтических препаратов.
- Исключить прием слабительных препаратов, введение ректальных свечей, масел, ограничить (по согласованию с врачом) прием медикаментов, влияющих на перистальтику кишечника (белладонна, пилокарпин и др.), и препаратов, влияющих на окраску кала (железо, висмут, сернокислый барий), в течение 72 часов до сбора кала.
Кишечные палочки - Escherichia coli - условно-патогенные микроорганизмы, обитающие в том числе в кишечнике человека. Большинство штаммов этой бактерии являются безвредными. Вирулентные кишечные палочки попадают в желудочно-кишечный тракт извне, как и возбудители других кишечных инфекций. Способность отдельных штаммов Е. coli вызывать заболевание связана с их способностью вырабатывать токсины, прикрепляться к стенке кишечника и внедряться в нее. Выделяют пять типов патогенных кишечных палочек, приводящих к развитию острых кишечных инфекций: энтеротоксигенные, энтеропатогенные, энтероинвазивные, энтерогеморрагические, энтероадгезивные.
Токсины энтеротоксигенных кишечных палочек способствуют избыточному выделению в просвет кишки воды и электролитов, развитию диареи и нарушений водно-электролитного баланса. Энтероинвазивные кишечные палочки внедряются в клетки слизистой оболочки толстой кишки, вызывают развитие в ней воспаления и образование эрозий. Энтерогеморрагические Е. coli вырабатывают шигаподобный токсин (токсин похожего действия продуцирует возбудитель дизентерии Shigella dysenteriae), который разрушает стенки мелких сосудов кишечной стенки, что приводит к появлению в кале крови и развитию ишемии и некроза стенки толстого кишечника. Энтероадгезивные кишечные палочки способны прочно прикрепляться к стенке кишечника и приводить к развитию длительной, но сравнительно легко протекающей кишечной инфекции.
Основным методом диагностики эшерихиозов является бактериологическое исследование. Биоматериал используют для посева на специальные питательные среды, и при отсутствии роста колоний микроорганизмов констатируется отрицательный результат посева.
Для чего используется исследование?
- Для верификации возбудителя острой кишечной инфекции.
Когда назначается исследование?
При развитии клинических проявлений острой кишечной инфекции (тошнота, рвота, схваткообразные боли в животе, частый, жидкий (водянистый), обильный стул, иногда с примесью слизи и крови);
при контакте пациента с лицом, у которого подтвержден диагноз "эшерихиоз".
Что означают результаты?
В норме патогенные эшерихии отсутствуют.
Отрицательный результат - нет роста - отсутствие роста микроорганизмов.
Положительный результат - есть рост - рост патогенного штамма Escherichia coli.
При обнаружении микроорганизма указывается серотип (ЭПЭ О 32) и чувствительность к а/б.
Важные замечания
- Интерпретация результатов данного исследования должна производиться исключительно специалистом в области медицины. При выявлении патогенных штаммов кишечной палочки необходимо обязательно проконсультироваться с врачом для решения вопроса о назначении лечения, в том числе при отсутствии выраженных симптомов заболевания.
- В отдельных рекомендациях признается целесообразным исследование как минимум трех образцов фекалий, собранных в разные дни, для верификации отрицательного результата у пациента с клиникой бактериальной кишечной инфекции.
Также рекомендуется
Посев кала на патогенную флору (диз. группа и тифопаратифозная группа) с определением чувствительности к антибиотикам
Посев кала на условно-патогенную флору с определением чувствительности к антибиотикам
Определение токсинов A и B Clostridium difficile
Анализ кала на яйца и личинки гельминтов, простейшие и их цисты (Parasep)
Кальпротектин в кале
Кто назначает исследование?
Инфекционист, педиатр, терапевт, врач общей практики, эпидемиолог, гастроэнтеролог.
Эшерихиозы ( Коли-инфекция )
Эшерихиозы – это острые, преимущественно кишечные инфекции, вызываемые некоторыми сероварами бактерии Escherichia coli. Эшерихиозы проявляются в виде энтерита и энтероколита, могут генерализоваться и протекать с внекишечной симптоматикой. Путь передачи кишечной палочки фекально-оральный. Чаще заражение происходит при употреблении зараженных молочных и мясных продуктов. Возможен и контактно-бытовой путь передачи кишечной инфекции. Диагноз эшерихиоза устанавливается при выявлении эшерихий в рвотных и каловых массах, а при генерализации инфекции - в крови. Лечение эшерихиозов состоит из диеты, регидратационной терапии, применения противомикробных средств и эубиотиков.
МКБ-10
Общие сведения
Эшерихиозы (коли-инфекции) - группа инфекций, вызываемой кишечной палочкой и протекающих с поражением ЖКТ, мочевых путей, респираторного тракта, мозговых оболочек, бактериемией. Чаще встречаются у детей раннего возраста. Наиболее распространены кишечные инфекции, вызванные эшерихией: они являются самой частой причиной диареи у младенцев и взрослых. Некоторые штаммы и их токсины вызывают жизнеугрожающие поражения внутренних органов.
Причины эшерихиозов
Escherichia coli (кишечная палочка) представляет собой короткие полиморфные грамотрицательные палочковидные бактерии, непатогенные штаммы которых присутствуют в составе нормальной кишечной флоры. Эшерихиоз вызывают диареегенные серовары следующих групп:
- энтеропатогенные (ЭПКП);
- энтеротоксигенные (ЭТКП);
- энтероинвазивные (ЭИКП);
- энтерогеморрагические (ЭГКП);
- энтероадгезивные (ЭАКП).
Эшерихии устойчивы во внешней среде, могут сохранять жизнеспособность в почве, воде и фекалиях до нескольких месяцев. В пищевых продуктах (в особенности в молоке) размножаются, образуя многочисленные колонии, легко переносят высушивание. Кишечные палочки погибают при кипячении и действии дезинфицирующих средств.
Эпидемиология
Резервуаром и источником инфекции являются больные люди или здоровые носители. Наибольшее эпидемическое значение в распространении возбудителя имеют лица, больные эшерихиозами, вызванными видами ЭПКП и ЭИКП, остальные группы бактерий менее опасны. Больные эшерихиозами, обусловленными заражением ЭТКП и ЭГКП контагиозны только в первые дни заболевания, в то время как ЭИКП и ЭПКП группы кишечных палочек выделяются больными 1-2 (иногда 3) недели. Выделение возбудителя может продолжаться довольно долго, в особенности у детей.
Механизм передачи кишечной палочки – фекально-оральный, чаще всего реализуется пищевой путь заражения для ЭТКП и ЭИКП и бытовой для ЭПКП. Кроме того, заражение может осуществляться водным путем. Пищевое заражение в основном происходит при употреблении молочных продуктов, мясных блюд, напитков (квас, компоты) и салатов с вареными овощами.
В детских коллективах и среди лиц, пренебрегающих правилами гигиены, возможно распространение кишечной палочки контактно-бытовым путем через загрязненные руки, предметы, игрушки. Заражение возбудителями группы ЭГПК часто происходит в результате употребления недостаточно кулинарно обработанного мяса, сырого непастеризованного молока. Отмечены вспышки эшерихиозов, вызванных употреблением гамбургеров.
Реализация водного пути заражения в настоящее время мало распространена, заражение водоемов кишечной палочкой обычно происходит при сбросе сточных вод без предварительного обезвреживания. Естественная восприимчивость к эшерихиозам высокая, после перенесения инфекции формируется нестойкий группоспецифический иммунитет.
Классификация
Эшерихиозы классифицируются по этиологическому принципу в зависимости от группы возбудителя (энтеропатогенные, энтеротоксические, энтероинвазивные, и энтерогеморрагические).
- Эшерихии группы ЭПКП – преимущественно вызывают эшерихиозы у детей, в особенности на первом году жизни. Вспышки, обусловленные этой группой кишечных палочек, как правило, возникают в яслях, детских садах, роддомах и детских отделения больниц. Заражение обычно происходит контактно-бытовым путем.
- Палочки группы ЭИКП вызывают энтероколиты, протекающие по типу дизентерии у детей старше года и взрослых. Заражение происходит водным и пищевым путем, отмечается летне-осенняя сезонность. Преимущественно распространены в развивающихся странах.
- ЭТКП вызывают инфекции холероподобного течения, заражаются дети от двух лет и взрослые, заболеваемость высока в странах с жарким климатом и низкой гигиенической культурой. Заражение происходит пищевым и водным путем.
- Эпидемиологических данных в отношении инфекций, возникающих в результате поражения возбудителем группы ЭГКП, в настоящее время недостаточно для детальной характеристики. В эпидемиологии эшерихиозов основное значение играют гигиенические мероприятия, как общего, так и индивидуального характера.
Существует клиническая классификация, выделяющая гастроэнтерическую, энтероколитическую, гастроэнтероколитическую и генерализованную формы заболевания. Генерализованная форма может быть представлена коли-сепсисом или поражением кишечной палочкой различных органов и систем (менингит, менингоэнцефалит, пиелонефрит и др.). Эшерихиоз может протекать в легкой, среднетяжелой и тяжелой форме.
Симптомы эшерихиоза
Энтеропатогенный эшерихиоз
ЭПКП I класса развивается обычно у детей младшего возраста, инкубационный период составляет несколько дней, проявляется преимущественно рвотой, жидким стулом, выраженной интоксикацией и дегидратацией. Есть вероятность развития генерализованной септической формы. Взрослые заболевают ЭПКП II класса, болезнь протекает по типу сальмонеллеза.
Энтероинвазивный эшерихиоз
Для поражения ЭИКП характерно течение наподобие дизентерии или шигеллеза. Инкубационный период длится от одного до трех дней, начало острое, отмечается умеренная интоксикация (головная боль, слабость), лихорадка в пределах от субфебрильных до высоких значений, озноб. Затем появляются боли в животе (преимущественно вокруг пупка), диарея (иногда с прожилками крови, слизью). Пальпация живота отмечает болезненность по ходу толстой кишки. Нередко эшерихиоз этого вида протекает в легкой и стертой форме, может отмечаться среднетяжелое течение. Обычно длительность заболевания не превышает нескольких дней.
Энтеротоксигенный эшерихиоз
Поражение ЭТКП может проявляться клиническими симптомами, сходными с таковыми при сальмонеллезе, пищевой токсикоинфекции или напоминать легкую форму холеры. Инкубационный период составляет 1-2 дня, интоксикация слабо выражена, температура обычно не повышается, отмечается многократная рвота, обильная энтеритная диарея, постепенно нарастает дегидратация, отмечается олигурия. Имеют место боли в эпигастральной области, носящие схваткообразный характер.
Эту инфекцию часто называют «болезнью путешественников», поскольку ей нередко страдают люди, выехавшие в командировку или на отдых в страны с тропическим климатом. Климатические условия способствуют возникновению выраженной лихорадки с ознобом и интоксикационными симптомами, интенсивному обезвоживанию.
Энтерогеморрагический эшерихиоз
ЭГКП развивается чаще всего у детей. Интоксикация при этом умеренная, температура тела субфебрильная. Имеет место тошнота и рвота, жидкий водянистый стул. При тяжелом течении к 3-4 дню, заболевания появляются сильные боли в животе схваткообразного характера, диарея усиливается, в испражнениях, утрачивающих каловый характер, могут отмечать примесь крови и гноя.
Чаще всего заболевание через неделю проходит самостоятельно, но при тяжелом течении (в особенности у детей младшего возраста) на 7-10 день, после исчезновения диареи, есть вероятность развития гемолитико-уремического синдрома (сочетание гемолитической анемии, тромбоцитопении и острой почечной недостаточности). Нередки нарушения мозговой регуляции: судороги конечностей, ригидность мускулатуры, нарушения сознания вплоть до сопора и комы. Летальность больных с развитием этой симптоматики достигает 5%.
Осложнения
Обычно эшерихиозы не склонны к осложнениям. В случае инфекции, спровоцированной возбудителем группы ЭГКП, есть вероятность возникновения осложнений со стороны мочевыделительной системы, гемолитическая анемия, церебральные расстройства.
Диагностика
Для диагностики эшерихиоза производится выделение возбудителя из кала и рвотных масс, в случаях генерализации – из крови, мочи, желчи или ликвора. После чего производится бактериологическое исследование, посев на питательных средах. В связи с антигенным сходством возбудителей эшерихиоза с бактериями, входящими в состав нормоциноза кишечника, серологическая диагностика малоинформативна.
Для лабораторной диагностики инфекций, вызванных ЭГКП, может применяться выявление бактериальных токсинов в испражнениях пациентов. При этом виде эшерихиозов в анализе крови могут быть отмечены признаки гемолитической анемии, повышение концентрации мочевины и креатинина. Анализ мочи обычно показывает протеинурию, лейкоцитурию и гематурию.
Лечение эшерихиоза
Лечение преимущественно амбулаторное, госпитализации подлежат больные с тяжелыми формами и высоким риском развития осложнений. Больным рекомендована диета. На период острых клинический проявлений (диареи) – стол №4, после прекращения – стол №13. Умеренная дегидратация корректируется приемом жидкости и регидратационных смесей перорально, при нарастании и выраженной степени обезвоживания производят внутривенное вливание растворов. Патогенетическое лечение выбирают в зависимости от вида возбудителя.
В качестве противомикробной терапии обычно назначаются препараты нитрофуранового ряда (фуразолидон), либо (при тяжелом течении инфекции, вызванной ЭИКП) фторхинолоны (ципрофлоксацин). Препараты назначают на 5-7 дней. Лечение эшерихиозов ЭПКП у детей целесообразно осуществлять с помощью комбинации сульфаметоксазола и триметоприма, антибиотикотерапии. Генерализованные формы лечат цефалоспоринами второго и третьего поколений.
В комплексную терапию при продолжительном течении заболевания для нормализации пищеварения и восстановления биоценоза кишечника включают ферментные препараты и эубиотики. Современные принципы лечения эшерихиозов, спровоцированных бактериями группы ЭГКП, включают применение антитоксических терапевтических мер (сыворотки, экстракорпоральная адсорбция антител).
Прогноз
Прогноз для взрослых и детей старшего возраста – благоприятный, при легком течении отмечаются случаи самостоятельного выздоровления. Дети раннего возраста могут страдать эшерихиозом в тяжелой форме, что ухудшает прогноз. Также заметно труднее идет выздоровление в случае генерализации и развития осложнений. Некоторые особо тяжелые формы эшерихиозов могут без должной медицинской помощи закончиться смертью.
Профилактика
Эшерихиозы – заболевания, связанные с низкой гигиенической культурой. Личная профилактика этих инфекций заключается в следовании гигиеническим нормам, в особенности при общении с детьми, мытье рук, пищевых продуктов, игрушек и предметов быта. Общая профилактика направлена на контроль соблюдения санитарно-гигиенического режима в детских учреждениях, предприятиях пищевой промышленности, лечебно-профилактических учреждениях, а также контроль над стоком канализационных отходов и состоянием источников воды.
Больные после перенесения эшерихиоза выписываются из стационара после клинического выздоровления, а также по результатам трехкратной бактериологической пробы. Допуск в коллектив детей, контактировавших с больным, также осуществляется после проведения бактериологической диагностики и подтверждения отсутствия выделения возбудителя. Лица, выделяющие патогенные эшерихии, подлежат изоляции на весь период контагиозности. Работники пищевой промышленности подвергаются регулярным обследованиям на предмет выделения возбудителя, в случае положительного теста – отстраняются от работы.
Энтеропатогенная инфекция, вызванная Escherichia coli (A04.0)
Эшерихиозы — группа бактериальных антропонозных инфекционных болезней, вызываемых патогенными (диареегенными) штаммами кишечной палочки, протекающих с симптомами общей интоксикации и поражением ЖКТ.

Автоматизация клиники: быстро и недорого!
- Подключено 300 клиник из 4 стран
- 800 RUB / 4500 KZT / 27 BYN - 1 рабочее место в месяц

Автоматизация клиники: быстро и недорого!
- Подключено 300 клиник из 4 стран
- 1 место - 800 RUB / 4500 KZT / 27 BYN в месяц
Мне интересно! Свяжитесь со мной
13-15 октября, Алматы, "Атакент"
600 брендов, более 150 компаний-участников из 20 стран.
Новинки рынка стоматологии. Цены от производителей
Этиология и патогенез
Эшерихии — подвижные грамотрицательные палочки, аэробы, относящиеся к виду Escherichia coli, роду Escherichia, семейству Enterobacteriaceae. Растут на обычных питательных средах, выделяют бактерицидные вещества-колицины. Морфологически серотипы не отличаются друг от друга. Эшерихии содержат соматические (О-Аг — 173 серотипа), капсульные (К-Аг — 80 серотипов) и жгутиковые (Н-Аг — 56 серотипов) антигены. Диареегенные кишечные палочки подразделяются на пять типов:
Факторы патогенности ЭТКП (пили, или фимбриальные факторы) определяют склонность к адгезии и колонизации нижних отделов тонкой кишки, а также к токсинообразованию. Термолабильный и термостабильный энтеротоксины ответственны за повышенную экскрецию жидкости в просвет кишки. Патогенность ЭПКП обусловлена способностью к адгезии. ЭИКП способны, имея плазмиды, проникать в клетки кишечного эпителия и размножаться в них. ЭГКП выделяют цитотоксин, шигоподобные токсины 1-го и 2-го типов, содержат плазмиды, которые облегчают адгезию к энтероцитам. Факторы патогенности энтероадгезивных кишечных палочек изучены недостаточно.
Эшерихии устойчивы в окружающей среде, могут месяцами сохраняться в воде, почве, испражнениях. Сохраняют жизнеспособность в молоке до 34 дней, в детских питательных смесях — до 92 дней, на игрушках — до 3-5 мес. Хорошо переносят высушивание. Обладают способностью размножаться в пищевых продуктах, особенно в молоке. Быстро погибают при воздействии дезинфицирующих средств и при кипячении. У многих штаммов Е. coli отмечают полирезистентность к антибиотикам.
Эшерихии проникают через рот, минуя желудочный барьер, и в зависимости от типовой принадлежности оказывают патогенное действие.
Энтеротоксигенные штаммы способны вырабатывать энтеротоксины и фактор колонизации, посредством которого осуществляются прикрепление к энтероцитам и колонизация тонкой кишки.
Энтеротоксины — термолабильные или термостабильные белки, которые воздействуют на биохимические функции эпителия крипт, не вызывая видимых морфологических изменений. Энтеротоксины усиливают активность аденилатциклазы и гуанилатциклазы. При их участии и в результате стимулирующего действия простагландинов увеличивается образование цАМФ, вследствие чего в просвет кишки секретируется большое количество воды и электролитов, которые не успевают реабсорбироваться в толстой кишке, — развивается водянистая диарея с последующими нарушениями водно-электролитного баланса. Инфицирующая доза ЭТКП — 10х10 10 микробных клеток.
ЭИКП обладают свойством внедряться в клетки эпителия толстой кишки. Проникая в слизистую оболочку, они вызывают развитие воспалительной реакции и образование эрозий кишечной стенки. Из-за повреждения эпителия усиливается всасывание в кровь эндотоксинов. У больных в испражнениях появляются слизь, кровь и полиморфно-ядерные лейкоциты. Инфицирующая доза ЭИКП — 5х10 5 микробных клеток.
Механизм патогенности ЭПКП изучен недостаточно. У штаммов (055,086,0111 и др.) выявлен фактор адгезии к клеткам Нер-2, за счёт которого происходит колонизация тонкого кишечника. У других штаммов (018, 044, 0112 и др.) этот фактор не обнаружен. Инфицирующая доза ЭПКП — 10х10 10 микробных клеток.
ЭГКП выделяют цитотоксин (SLT — shiga-like toxin), который разрушает клетки эндотелия, выстилающего мелкие кровеносные сосуды кишечной стенки проксимальных отделов толстой кишки. Сгустки крови и фибрин препятствуют кровоснабжению кишки — в кале появляется кровь. Развивается ишемия кишечной стенки, вплоть до некроза. У некоторых больных наблюдают осложнения с развитием синдрома диссеминированного внутрисосудистого свёртывания (ДВС), ИТШ и ОПН.
ЭАКП способны к колонизации эпителия тонкой кишки. Вызванные ими заболевания взрослых и детей протекают длительно, но легко. Это связано с тем, что бактерии прочно закрепляются на поверхности эпителиальных клеток.
Основной источник эшерихиозов — больные со стёртыми формами заболевания, меньшую роль играют реконвалесценты и носители. Значимость последних возрастает, если они работают на предприятиях по приготовлению и реализации пищевых продуктов. По некоторым данным, источник возбудителя при энтерогеморрагических эшерихиозах (0157) — крупный рогатый скот. Инфицирование людей происходит при употреблении продуктов, которые были недостаточно термически обработаны. Механизм передачи — фекально-оральный, который осуществляется пищевым, реже — водным и бытовым путём. По данным ВОЗ, для энтеротоксигенных и энтероинвазивных эшерихии характерен пищевой, а для энтеропатогенных — бытовой путь.
Из пищевых продуктов чаще фактором передачи служат молочные изделия, готовые мясные продукты, напитки (квас, компот и др.).
В детских коллективах инфекция может распространяться через игрушки, загрязнённые предметы обихода, руки больных матерей и персонала. Реже регистрируют водный путь передачи эшерихиозов. Наиболее опасно загрязнение открытых водоёмов, которое происходит в результате сброса необезвреженных хозяйственно-бытовых сточных вод, особенно из детских учреждений и инфекционных больниц.
Восприимчивость к эшерихиозам высока, особенно среди новорождённых и ослабленных детей. Около 35% детей, которые общались с источником инфекции, становятся носителями. У взрослых восприимчивость повышается в связи с переездом в другую климатическую зону, с изменением характера питания и т.д. («диарея путешественников»). После перенесённого заболевания формируется кратковременный непрочный типоспецифический иммунитет.
Основу профилактики эшерихиозов составляют меры по пресечению путей передачи возбудителя. Особенно важно соблюдать санитарно-гигиенические требования на объектах общественного питания, водоснабжения; предупреждать контактно-бытовой путь заражения в детских учреждениях, родильных домах, стационарах (использование индивидуальных стерильных пелёнок, обработка рук дезинфицирующими растворами после работы с каждым ребёнком, дезинфекция посуды, пастеризация, кипячение молока, молочных смесей). Продукты, готовые к употреблению, и сырые, нужно разделывать на разных досках отдельными ножами. Посуду, в которой транспортируют пищу, необходимо обрабатывать кипятком.
При подозрении на эшерихиоз необходимо обследовать беременных до родов, рожениц, родильниц и новорождённых.
Контактных в очаге заболевания наблюдают 7 дней. Детей, контактных с больным эшерихиозом по месту жительства, допускают в детские учреждения после разобщения с больным и трёхкратных отрицательных результатов бактериологического исследования кала.
При выявлении больных эшерихиозом в детских учреждениях и родильных домах прекращают приём поступающих детей и рожениц. Персонал, матери, дети, бывшие в контакте с больным, а также дети, выписанные домой незадолго до заболевания, обследуются трёхкратно (проводят бактериологическое исследование кала). При выявлении лиц с положительными результатами обследования их изолируют. Больных, перенёсших эшерихиоз, наблюдают в течение 3 мес с ежемесячным клиническим и бактериологическим обследованием в КИЗ. Перед снятием с учёта — двукратное бактериологическое исследование кала с интервалом в 1 день.
Клиническая картина
Cимптомы, течение
Клинические проявления эшерихиозов зависят от типа возбудителя, возраста больного, иммунного статуса.
При эшерихиозе, вызванном энтеротоксигенными штаммами, инкубационный период — 16-72 ч, для него характерно холероподобное течение болезни, протекающее с поражением тонкой кишки без выраженного синдрома интоксикации («диарея путешественников»).
Заболевание начинается остро, больных беспокоят слабость, головокружение. Температура тела нормальная или субфебрильная. Появляются тошнота, повторная рвота, разлитые схваткообразные боли в животе. Стул частый (до 10-15 раз в сутки), жидкий, обильный, водянистый, нередко напоминающий рисовый отвар. Живот вздут, при пальпации определяют урчание, небольшую разлитую болезненность. Тяжесть течения определяется степенью дегидратации. Возможна молниеносная форма заболевания с быстрым развитием эксикоза. Длительность болезни 5-10 дней.
Особенности эшерихиоза, вызванного энтероадгезивными штаммами, изучены мало. Заболевание регистрируют у пациентов с ослабленной иммунной системой. Чаще выявляют внекишечные формы — поражение мочевыводящих (пиелонефрит, цистит) и желчевыводящих (холецистит, холангит) путей. Возможны септические формы (коли-сепсис, менингит).
Клиническая картина эшерихиозов сходна с клинической картиной других диарейных инфекций. Поэтому диагноз подтверждают на основании бактериологического метода исследования. Материал (испражнения, рвотные массы, промывные воды желудка, кровь, моча, ликвор, жёлчь) следует брать в первые дни болезни до назначения больным этиотропной терапии. Посевы производят на среды Эндо, Левина, Плоскирева, а также на среду обогащения Мюллера.
Используют иммунологические методы исследования РА, РИГА в парных сыворотках, но они не убедительны, так как возможны ложноположительные результаты из-за антигенного сходства с другими энтеробактериями. Эти методы используют для ретроспективной диагностики, особенно во время вспышки.
Перспективным методом диагностики служит ПЦР. Инструментальные методы исследования (ректороманоскопия, колоноскопия) при эшерихиозах малоинформативны.
Дифференциальный диагноз
Дифференциальную диагностику эшерихиозов проводят с другими острыми диарейными инфекциями: холерой, шигеллёзом, сальмонеллёзом, кампилобактериозом, ПТИ стафилококковой этиологии и вирусными диареями: ротавирусной, энтеровирусной, Норволк-вирусной инфекцией и др.
В отличие от эшерихиозов, холера характеризуется отсутствием интоксикации, лихорадки, болевого синдрома, наличием многократной рвоты, быстрым развитием дегидратации III-IV степени. Помогает в постановке диагноза эпидемиологический анамнез — пребывание в эндемичных для холеры регионах.
Шигеллёзу, в отличие от эшерихиозов, свойственна высокая лихорадка, боли локализуются в левой подвздошной области. Пальпируют спазмированную, болезненную сигму. Стул скудный, в виде «ректального плевка».
Сальмонеллёз, в отличие от эшерихиозов, характеризуется более выраженной интоксикацией, разлитыми болями в животе, болезненностью при пальпации в эпигастральной и околопупочной областях, урчанием. Характерен зловонный стул зеленоватого цвета.
Для ПТИ стафилококковой этиологии, в отличие от эшерихиозов, характерны острое, бурное начало заболевания, короткий инкубационный период (30-60 мин), более выражены симптомы интоксикации, рвота неукротимая. Боли в животе режущего характера, с локализацией в эпигастральной и околопупочной областях. Характерны групповой характер заболевания, связь заболевания с пищевым фактором, быстрый регресс болезни.
Ротавирусному гастроэнтериту, в отличие от эшерихиозов, свойственны катаральные явления, изменения слизистой оболочки ротоглотки (гиперемия, зернистость), слабость, адинамия. Боли в животе диффузные, стул жидкий, «пенистый», с резким, кислым запахом, позывы на дефекацию носят императивный характер. При пальпации отмечают «крупнокалиберное» урчание в области слепой, реже сигмовидной кишки.
Чаще эшерихиозы протекают доброкачественно, но возможны осложнения: ИТШ, гиповолемический шок с дегидратацией III-IV степени, ОПН, сепсис, пневмония, пиелоцистит, пиелонефрит, холецистит, холангит, менингит, менингоэнцефалит. Летальный исход в результате ОПН (синдром Гассера) регистрируют у детей до 5 лет в 3-7% случаев. В Москве за последние 10 лет летальных исходов не было.
Лечение
В остром периоде болезни больным рекомендуют щадящую терапию (стол № 4, при нормализации стула — № 2, в период реконвалесценции — № 13).
В лёгких случаях заболевания достаточно назначения оральной регидратационной терапии (регидрон и другие растворы, количество которых должно в 1,5 раза превышать потери воды с испражнениями).
Показаны ферменты (панзинорм-форте, мезим-форте), энтеросорбенты (полисорб, энтеросгель, энтеродез в течение 1-3 дней). При лёгком течении болезни целесообразно использование кишечных антисептиков (интетрикс по две капсулы три раза в день, неоинтестопан после каждого акта дефекации по две таблетки, до 14 в сутки, энтерол по две капсулы два раза в день) в течение 5-7 дней. Лёгкие и стёртые формы эшерихиозов не требуют назначения этиотропных препаратов.
При лечении больных в условиях стационара показан постельный режим в первые 2-3 дня. Назначают этиотропную терапию. С этой целью при среднетяжёлых формах используют один из следующих препаратов: ко-тримоксазол по две таблетки два раза в день или препараты фторхинолонового ряда (ципрофлоксацин по 500 мг два раза в сутки перорально, пефлоксацин по 400 мг два раза в сутки, офлоксацин по 200 мг два раза в сутки), длительность терапии 5-7 дней.
В тяжёлых случаях фторхинолоны применяют вместе с цефалоспоринами 2-го (цефуроксим по 750 мг четыре раза в сутки внутривенно или внутримышечно; цефаклор по 750 мг три раза в сутки внутримышечно; цефтриаксон 1,0 г один раз в сутки внутривенно) и 3-го поколения (цефоперазон по 1,0 г два раза в сутки внутривенно или внутримышечно; цефтазидим по 2,0 г два раза в сутки внутривенно или внутримышечно).
При дегидратации II-III степени назначают регидратационную терапию внутривенно кристаллоидными растворами (хлосоль, ацесоль и пр.), которую проводят по общим правилам.
При выраженных симптомах интоксикации используют коллоидные растворы (декстран и др.) в объёме 400-800 мл/сут.
После приёма антибактериальных препаратов при продолжающейся диарее используют эубиотики для коррекции дисбактериозов (бифидумбактерин-форте, хилак-форте и др.) в течение 7-10 дней. Больных выписывают после полного клинического выздоровления, нормализации стула и температуры тела, а также однократного бактериологического исследования кала, которое проводят не ранее чем через 2 дня после окончания лечения.
При лёгкой форме заболевания 5-7 дней, при среднетяжёлой 12-14 дней, при тяжёлой — 3-4 нед. Диспансеризация не регламентирована.
Госпитализация
Госпитализацию больных с эшерихиозами проводят по клиническим и эпидемиологическим показаниям. Больных при среднетяжёлом и тяжёлом течении заболевания госпитализируют в инфекционные больницы. В лёгких случаях больные могут лечиться амбулаторно при наличии благоприятных бытовых, санитарно-гигиенических условий.
По эпидемиологическим показаниям госпитализации подлежат лица из декретированных групп, больные из организованных коллективов, а также пациенты, проживающие в коммунальных квартирах, общежитиях.
Читайте также:
- Снотворные средства. Идиопатическая бессонница.
- Ингибиторы ДНК-полимераз ДНК-содержащих вирусов. Видарабин. Идоксуридин. Трифторидин ( вироптик ). Ацикловир. Фамцинловир. Ганцикловир. Фоскарнет.
- Прямокишечно-влагалищный свищ при раке шейки матки, влагалища или вульвы
- Методы диагностики ретинобластомы
- КТ, МРТ при денервационной гипертрофии
